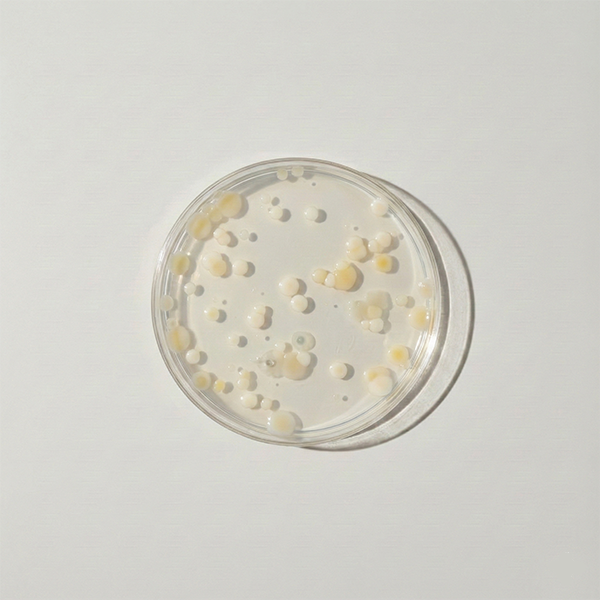
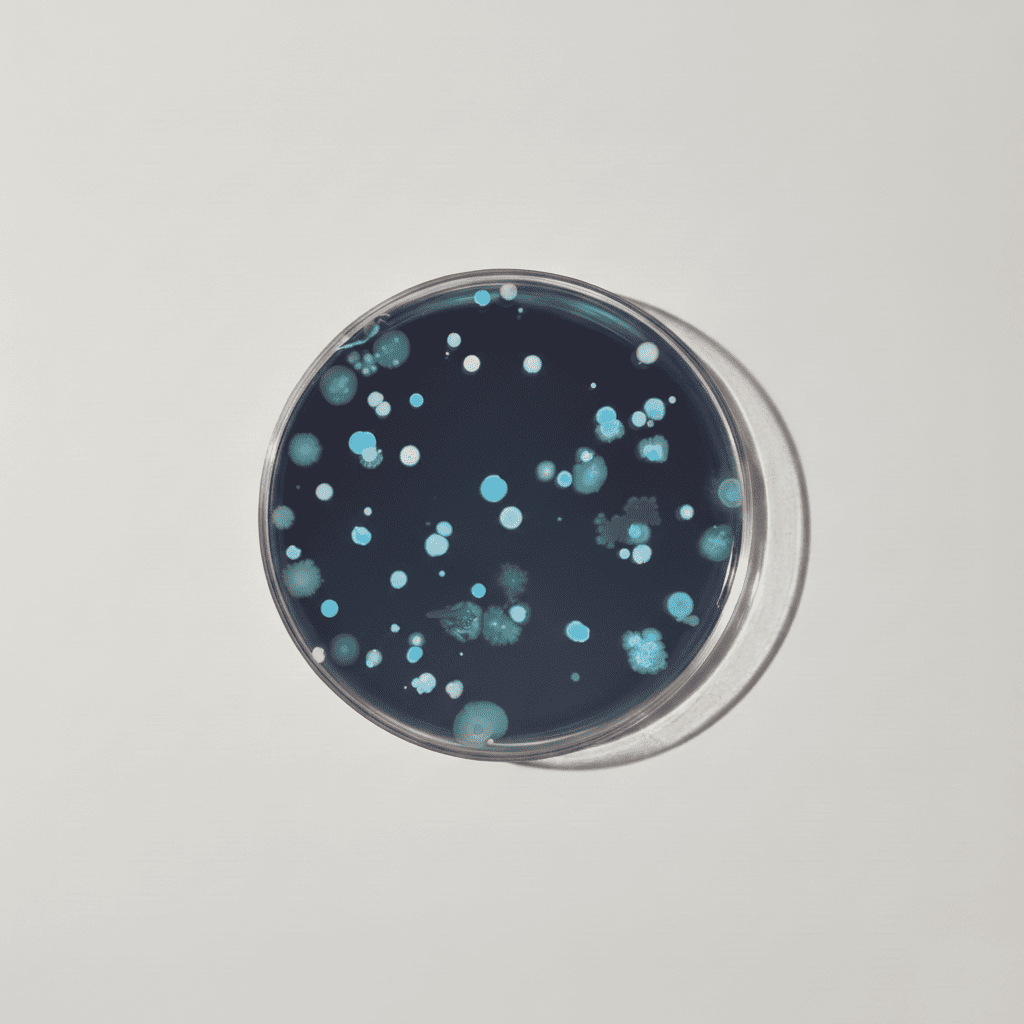

Fruits & Légumes
Source naturelle de vitamines, minéraux, fibres et antioxydants, les fruits et légumes apportent les micronutriments essentiels au bon fonctionnement de l’organisme. Ils soutiennent l’immunité, la digestion et la protection cellulaire, tout en participant à l’équilibre nutritionnel global au quotidien.
Valeurs nutritionnelles
Fruits & Légumes
-

Pomme
Biologique certifiée -

Citron
Biologique certifiée -

Ananas
Biologique certifiée -

Framboise
Biologique certifiée -

Fraise
Biologique certifiée -

Aronia
Biologique certifiée -

Brocoli
Biologique certifiée -

Épinard
Biologique certifiée -

Betterave
Biologique certifiée -

Carotte
Biologique certifiée -

Potiron
Biologique certifiée
Vitamines & Minéraux
-

Vitamine A
Rétinol -

Vitamine B1
Thiamine -

Vitamine B2
Riboflavine-5’-phosphate -

Vitamine B3
Niacine -

Vitamine B5
d-pantothénate de cal... -

Vitamine B6
P5P -

Vitamine B8
biotine -

Vitamine B9
L-méthylfolate Extraf... -

Vitamine B12 Méthylcobalamine
Méthylcobalamine -

Vitamine C
Acérola + cynorrhodon -

Vitamine D3
Cholécalciférol -

Vitamine E
D-alpha tocophérol na... -

Vitamine K2
MK-7 -

Magnésium
Bisglycinate -

Zinc
Gluconate -

Fer
Fumarate -

Sélénium
L-selenometionine -

Chrome
Picolinate -

Cuivre
Gluconate -

Calcium
Lactate
Probiotiques
-

Bifidobacterium lactis
BL-04 -

Lactobacillus acidophilus
LA-14
Superaliments & Antioxydants
-

Spiruline
-

Protéines de fèves
-

Chlorelle
-

Herbe de blé
Sans gluten -

Herbe d’orge
-

Lécithine de tournesol
Phosphatidylcholine -

Artichaut
-

Gingembre
-

Ginseng sibérien
-

Cacao
-

Baie de goji
-

Lion’s Mane
-

Reishi
-

Rose musquée
-

Acérola
vitamine C naturelle -

Coenzyme Q10
Ubiquinone -

Grenade
-

Poivre noir
-

Huile de coco
MCT -

Policosanol
-

Acide malique
Plantes
-

Chardon-Marie
-

Mélisse
-

Orme Rouge
-

Aubépine
-

Moringa
-

Bacopa
-

Fleur de lavande
-

Racine de bardane
-

Rhodiola rosea
-

Aigremoine
-

Huile d’onagre
GLA
Enzymes Digestives, Fibres & Prébiotiques
-

Racine de chicorée
Inuline -

Fructo-oligosaccharides
FOS -

Beta-glucanes d’avoine
PromOat ® -

Fibre d'acacia
-

DigeZymes®
Complexes d'enzymes d...
Arômes naturels
-

Aromes naturels

UNE QUALITÉ CERTIFIÉE
Chaque lot de NUORO est rigoureusement testé par un laboratoire indépendant français pour garantir sécurité, conformité et pureté.
4 métaux lourds
Chaque lot est analysé en laboratoire pour garantir l’absence de métaux lourds (plomb, arsenic, cadmium, mercure) au-delà des seuils fixés par la réglementation européenne.
552 résidus de pesticides
Vérification de l’absence de résidus de pesticides.
5 contaminants microbiens
Contrôle de l’absence de contaminants microbiens.
Présence de gluten

De Multiples Bénéfices dans chaque stick
Chez NUORO, chaque ingrédient a été soigneusement sélectionné pour une absorption optimale et une synergie parfaite, afin de maximiser leurs bienfaits.

Nous VS eux
Qualité, transparence et un prix juste.

|
Tout-en-unclassiques | |
|---|---|---|
| Légitimité |
N°1 en France |
Arrivés après |
| Transparence |
Totale |
🤔 |
| Goût |
😋 |
🤢 |
| Synergie |
|
|
| Qualité |
tests en laboratoire |
Ingrédients génériques |
| Dosages |
Physiologiques, Sûrs, Efficaces |
Sous-dosés |
| Prix |
Prix juste 💛 Meilleur densité nutritonnelle /€ du marché |
Prix gonflés 👎 au regard de la concentration réelle en actifs |
"Nous avons conçu NUORO avec une exigence simple : réunir, en un seul geste, les nutriments essentiels dont le corps a besoin chaque jour. Chaque ingrédient a été sélectionné pour sa qualité, son dosage et sa place dans une formule pensée en synergie. Je suis fier d'avoir contribué à ce projet."

Des questions ?
Vous ne trouvez pas de réponses à vos questions ? Contactez nous ici :
hello@drinknuoro.com-
Quelle est la composition de NUORO ?
NUORO contient 71 ingrédients répartis en plusieurs familles complémentaires :
fruits et légumes, vitamines, minéraux, probiotiques et prébiotiques, antioxydants, superaliments, extraits de plantes, adaptogènes et enzymes digestives.
Cette composition a été pensée pour agir de façon globale et synergique, afin de soutenir la digestion, l’énergie, l’immunité et l’équilibre général au quotidien.
Pour le détail complet des ingrédients et des dosages, vous pouvez consulter la fiche nutritionnelle officielle NUORO, validée avec nos laboratoires. -
Pourquoi NUORO contient-il autant d’ingrédients ?
Parce que le corps ne fonctionne pas avec un seul nutriment à la fois.
NUORO associe 71 ingrédients issus de différentes familles (fruits, légumes, vitamines, minéraux, probiotiques, plantes, antioxydants…) pour agir de manière globale sur la digestion, l’énergie, l’immunité et l’équilibre général.
Chaque ingrédient a un rôle précis, et c’est leur synergie qui permet d’obtenir des effets plus complets qu’avec des ingrédients isolés. -
Est-ce que les fruits et légumes utilisés dans NUORO sont bio ?
Nous utilisons des fruits et légumes issus de l’agriculture biologique certifiée, tels que la pomme, le citron, l’ananas, le brocoli, les épinards, la carotte, la betterave, la framboise, la fraise ou l’aronia.
-
Pourquoi certains ingrédients dépassent-ils les 100 % des VNR ?
Les VNR (valeurs nutritionnelles de référence) correspondent à un minimum recommandé, pas à une limite à ne pas dépasser.
Certains nutriments sont donc dosés au-delà de 100 % pour garantir un apport réellement efficace, surtout face aux carences silencieuses, au stress, au sport ou à la qualité variable de l’alimentation.
Les dosages utilisés dans NUORO sont optimisés pour une consommation quotidienne.
En résumé : dépasser 100 %, c’est parfois ce qu’il faut pour bien couvrir vos besoins — sans jamais compromettre la sécurité. -
Les ingrédients de NUORO peuvent-ils entrer en conflit entre eux ?
Non. La formule NUORO a été conçue pour éviter les interactions négatives.
Les ingrédients sont sélectionnés, dosés et combinés pour fonctionner ensemble, dans une logique de synergie, et non de compétition.
Chaque composant a été intégré en tenant compte de sa tolérance, de son absorption et de son interaction avec les autres, afin de garantir une consommation quotidienne sûre et équilibrée. -
Pourquoi la synergie des ingrédients est-elle importante ?
Parce que certains nutriments sont plus efficaces lorsqu’ils agissent ensemble.
Dans NUORO, vitamines, minéraux, fibres, probiotiques et plantes se complètent et se renforcent, ce qui améliore à la fois leur absorption et leurs effets.
C’est cette action combinée — plutôt que des ingrédients isolés — qui permet des bénéfices plus complets et durables. -
Pourquoi NUORO n’est-il pas proposé sous forme de gélules ?
Parce que la formule NUORO contient environ 12 g de poudre par jour, soit l’équivalent de 17 gélules.
Proposer NUORO sous forme de capsules serait peu pratique, moins agréable et moins efficace.
La forme poudre permet aussi une meilleure assimilation, une action plus rapide dès la digestion, et évite l’ajout d’enveloppes ou d’excipients inutiles.
Un seul geste, simple et savoureux :) -
Pourquoi la synergie des ingrédients est-elle importante ?
Parce que certains nutriments fonctionnent mieux ensemble que seuls.
Dans NUORO, vitamines, minéraux, probiotiques, fibres, plantes et superaliments se renforcent mutuellement, améliorant à la fois l’efficacité et l’assimilation.
C’est cette combinaison — plutôt que des ingrédients isolés — qui permet d’obtenir des effets plus complets et durables.
-
Peut-on consommer NUORO tous les jours ?
Oui. NUORO est conçu pour une consommation quotidienne, à raison d’un stick par jour.
C’est la régularité qui permet aux ingrédients d’agir pleinement et aux bienfaits de s’installer dans le temps. -
Comment prendre NUORO ?
Versez 1 stick de NUORO dans 250 ml d’eau fraîche, dans votre shaker NUORO.
Secouez 5 à 10 secondes, puis savourez.
Idéalement, prenez-le le matin à jeun.
Mais le plus important reste la régularité : choisissez le moment qui s’intègre le mieux à votre routine quotidienne. -
Est-ce que NUORO se prend en cure ?
NUORO est avant tout conçu pour une prise continue, comme une routine quotidienne tout au long de l'année.
Ses bienfaits se construisent dans le temps et s’installent grâce à la régularité.
Cela dit, NUORO peut aussi être consommé en cure saisonnelle lors de périodes spécifiques : stress intense, fatigue passagère, changements de rythme.
Dans tous les cas, un stick par jour suffit pour soutenir le corps au moment où il en a le plus besoin. -
Puis-je mélanger NUORO avec autre chose que de l’eau ?
Oui. Vous pouvez mélanger NUORO avec de l’eau de coco, du lait végétal, un jus léger ou l’intégrer dans un smoothie.
-
Peut-on consommer NUORO tous les jours ?
Oui. NUORO est conçu pour une consommation quotidienne, à raison d’un stick par jour.
C’est la régularité qui permet aux ingrédients d’agir pleinement et aux bienfaits de s’installer dans le temps.
-
Comment NUORO garantit-il l’efficacité de ses ingrédients ?
L’efficacité de NUORO repose sur trois piliers : la qualité des ingrédients, des dosages optimisés et la synergie de la formule.
La formule est développée en laboratoire avec des nutritionnistes et des biologistes, afin de sélectionner les ingrédients les plus pertinents et les formes les mieux assimilées.
Chaque lot est ensuite testé par des laboratoires indépendants pour vérifier la conformité, la qualité et la sécurité avant sa mise sur le marché, afin de garantir une consommation quotidienne à la fois sûre et efficace. -
Comment NUORO mesure-t-il la qualité des ingrédients ?
La qualité de NUORO commence par une sélection rigoureuse de nos fournisseurs, choisis pour leur expertise, leur traçabilité et le respect des normes européennes.
Chaque ingrédient est évalué pour sa pureté, sa biodisponibilité et sa cohérence avec la formule.
La recette NUORO est le résultat de plus de 24 mois de recherche et développement, menés avec des experts en nutrition et en biologie, afin d’optimiser les ingrédients, leurs formes et leurs dosages pour une utilisation quotidienne sûre et efficace. -
NUORO a-t-il été testé en laboratoire ?
Oui. La formule NUORO est développée et contrôlée en laboratoire.
Chaque lot fait l’objet d’analyses pour vérifier la qualité, la conformité nutritionnelle et la sécurité avant sa mise sur le marché.